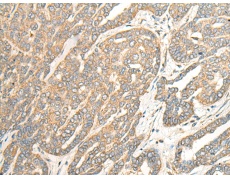
一抗

別 名: BRI; FBD; ABRI; BRI2; E25B; E3-16; RDGCA; imBRI2; BRICD2B
抗 原: ITM2B
標 記 物: Unconjugate
技術(shù)規(guī)格
|
Background: |
Amyloid precursor proteins are processed by beta-secretase and gamma-secretase to produce beta-amyloid peptides which form the characteristic plaques of Alzheimer disease. This gene encodes a transmembrane protein which is processed at the C-terminus by furin or furin-like proteases to produce a small secreted peptide which inhibits the deposition of beta-amyloid. Mutations which result in extension of the C-terminal end of the encoded protein, thereby increasing the size of the secreted peptide, are associated with two neurogenerative diseases, familial British dementia and familial Danish dementia. |
|
Applications: |
ELISA, WB, IHC |
|
Name of antibody: |
ITM2B |
|
Immunogen: |
Fusion protein of human ITM2B |
|
Full name: |
integral membrane protein 2B |
|
Synonyms: |
BRI; FBD; ABRI; BRI2; E25B; E3-16; RDGCA; imBRI2; BRICD2B |
|
SwissProt: |
Q9Y287 |
|
ELISA Recommended dilution: |
5000-10000 |
|
IHC positive control: |
Human liver cancer |
|
IHC Recommend dilution: |
30-150 |
|
WB Predicted band size: |
30 kDa |
|
WB Positive control: |
Rat kidney tissue lysate |
|
WB Recommended dilution: |
500-2000 |


 購物車
購物車 幫助
幫助
 021-54845833/15800441009
021-54845833/15800441009